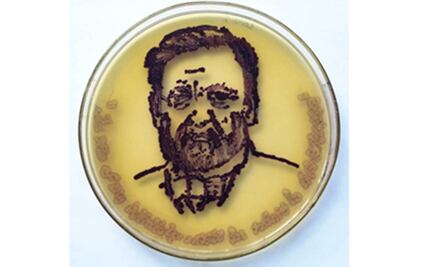
Crean obras de arte con microbios

En tus ojos viven estos microbios
Los microbios que viven en el ojo son esenciales para las respuestas inmunes que protegen al ojo de la infección

Los microbios que viven en el ojo son esenciales para las respuestas inmunes que protegen al ojo de la infección

Para los perros, por ejemplo, hay tres parásitos que son especialmente peligrosos

Lavarse con agua y jabón puede salvar vidas, ya que esta acción previene numerosas enfermedades

Científicos de todo el mundo criticaron la falta vigilancia y prevención respecto a la última epidemia de ébola

Un estudio recalca los beneficios de convivir con estos microorganismos en casa e, incluso, sugiere tenerlo en cuenta en el diseño de las viviendas

Científicos españoles participan en el proyecto de investigación internacional Metasub, que pretende cartografiar el microbioma de los sistemas de transporte público de 54 ciudades en todo el mundo, incluyendo la Ciudad de México.
Científicos resaltaron la belleza oculta en las bacterias

Entre los más comunes están las bacterias estafilococos y estreptococos